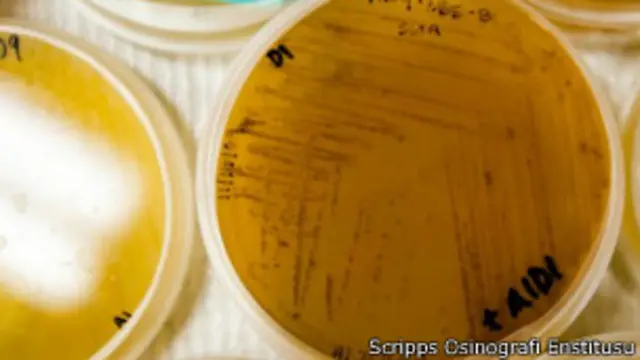

Okyanus çamurundan 'süper antibiyotik'
ABD'nin Kalifoniya eyaleti kıyılarındaki okyanus çökeltisinde bulunan bir mikroorganizmada yeni bir antibiyotik keşfedildi.
Gerçek yeni antibiyotik keşifleri nadiren yapılıyor ve uzmanlar antibiyotik ilaçlara karşı gelişen direncin insan sağlığına büyük bir tehdit oluşturduğunu söylüyor.
ABD'li biliminsanlarının keşfettiği antrasimisin adlı antibiyotiğin hastane mikrobu, ya da süper virüs diye bilinen Metisilin dirençli Stafilokok Auerus ve şarbona karşı etkin olduğu açıklandı.
Alman bilim dergisi Angewandte Chemie'de yayımlanan keşifle, yeni sınıf bir dizi antibiyotik ilacın üretilebileceği kaydediliyor.
ABD Hastalık Kontrol ve Önleme Merkezleri Direktörü Thomas Frieden geçtiğimiz günlerde antibiyotiklere karşı dirençli virüsleri 'kâbus' diye tanımlamış, İngiltere Sağlık Bakanlığı Baş Danışmanı Sally Davies de bu tür virüslerin bir 'saatli bomba' olduğunu söylemişti.
ABD Salgın Hastalıklar Derneği de, virüslerde gelişen dirence karşı antibiyotik gelişiminin yetersiz olduğundan kaygı duyulduğunu belirtmişti.
Bu nedenle, bu yeni antibiyotik keşfi tıp dünyası açısından özellikle memnuniyet verici bir haber olarak değerlendiriliyor.
Scripps Araştırma Enstitüsü'nden Kyoung Hwa Jang ve çalışma arkadaşlarının makalesine göre, yeni antibiyotiğin yapısı daha önce bulunan doğal antibiyotiklerden tamamen farklı.
Okyanuslardaki potansiyel
Yeni antibiyotik Christopher Kauffman'ın Büyük Okyanus'ta topladığı çökeltilerde bulunan Streptomisis adlı bakteriden üretildi.
Araştırma ekibinin başkanı William Fenical, 'Bu çalışmanın asıl önemi antrasimisinde yeni ve eşsiz bir kimyasal yapı olması. Gerçekten yeni bir kimyasal yapı keşfedilmesi çok nadir görülen bir durum. Bu keşif, daha önce deniz bakterilerinin genetik ve kimyasal açıdan eşsiz olduğunu gösteren daha önceki keşifleri destekler nitelikte' dedi.
Yeni antibiyotiğin ilk denemelerinde biyolojik terör silahı olarak kullanılan şarbona ve süper virüslere karşı etkin olduğunu ortaya koydu.
Keşifle aynı zamanda, çoğu araştırılmayı bekleyen okyanuslardaki yeni materyallerin önemi ortaya çıkmış oldu.








